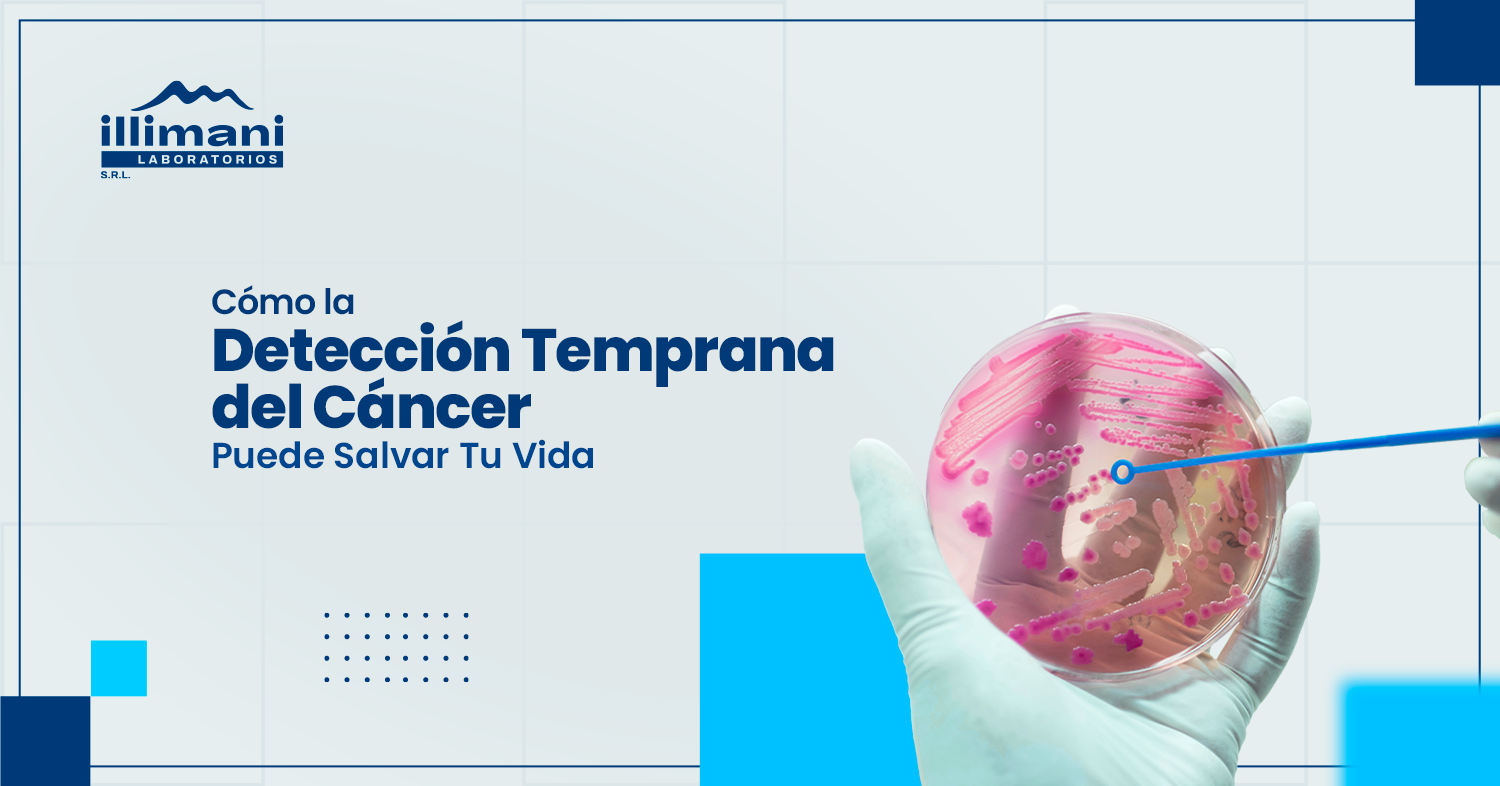

El cáncer es una de las principales causas de muerte en todo el mundo, pero con la detección temprana, las posibilidades de tratamiento exitoso y recuperación aumentan considerablemente.
En este artículo, exploraremos las pruebas de laboratorio esenciales para la detección temprana del cáncer y cómo estas pueden marcar la diferencia entre la vida y la muerte.
El Poder de la Detección Temprana: La detección temprana del cáncer significa identificar la enfermedad en sus primeras etapas, cuando es más tratable. Muchas veces, el cáncer en fase inicial no presenta síntomas evidentes, lo que hace que las pruebas de detección sean cruciales.
Pruebas de Laboratorio Esenciales para la Detección del Cáncer
Papanicolaou y Prueba de VPH
- Qué son: El Papanicolaou (o citología cervical) detecta cambios anormales en las células del cuello uterino, mientras que la prueba de VPH (virus del papiloma humano) identifica infecciones por tipos de VPH de alto riesgo.
- Por qué son importantes: Son esenciales para la detección temprana del cáncer cervical, uno de los cánceres más prevenibles si se detecta a tiempo.
- Cuándo realizarlas: Las mujeres deben comenzar a realizarse estas pruebas a partir de los 21 años, y la frecuencia depende de los resultados anteriores y la edad.
Antígeno Prostático Específico (PSA)
- Qué es: Es un análisis de sangre que mide el nivel de PSA, una proteína producida por la glándula prostática.
- Por qué es importante: Niveles elevados de PSA pueden ser un signo de cáncer de próstata, aunque también pueden ser causados por otras condiciones.
- Cuándo realizarlo: Generalmente, se recomienda para hombres mayores de 50 años, pero aquellos con antecedentes familiares de cáncer de próstata deberían considerar empezar antes.
Mamografía
- Qué es: Es una radiografía de las mamas que puede detectar tumores que son demasiado pequeños para ser palpados.
- Por qué es importante: Es la herramienta más eficaz para la detección temprana del cáncer de mama, el cual tiene una alta tasa de curación cuando se trata en las etapas iniciales.
- Cuándo realizarla: Se recomienda anualmente o cada dos años para mujeres mayores de 40 años, aunque la frecuencia puede variar según el riesgo individual.
Colonoscopia
- Qué es: Es un examen que permite al médico ver el interior del colon y el recto utilizando un tubo largo y flexible con una cámara en su extremo.
- Por qué es importante: Puede detectar pólipos precancerosos que pueden ser removidos antes de que se conviertan en cáncer colorrectal.
- Cuándo realizarla: Se recomienda comenzar a los 50 años, o antes si tienes antecedentes familiares de cáncer colorrectal.
Importancia de la Detección Temprana del Cáncer
- Mejores Resultados del Tratamiento: El cáncer detectado en etapas tempranas suele ser más tratable y curable. Los tratamientos son menos invasivos y las tasas de supervivencia son significativamente más altas.
- Menos Impacto Emocional y Financiero: El tratamiento de cáncer avanzado no solo es más complejo y costoso, sino que también tiene un impacto emocional considerable en el paciente y su familia. Detectar el cáncer temprano puede reducir significativamente estos desafíos.
- Mayor Tranquilidad: Realizar pruebas de detección de cáncer regularmente te brinda la tranquilidad de saber que estás cuidando tu salud de manera proactiva.
Consejos para la Detección Temprana
- Consulta con tu Médico Regularmente: Discute tu historial médico y cualquier factor de riesgo con tu médico para determinar qué pruebas de detección son apropiadas para ti.
- Conoce tus Factores de Riesgo: Si tienes antecedentes familiares de cáncer o llevas un estilo de vida con factores de riesgo, como el tabaquismo, es crucial que sigas un plan de detección personalizado.
- Mantente Informado: Aprende sobre los síntomas tempranos de los diferentes tipos de cáncer para que puedas buscar atención médica rápidamente si notas algo inusual.
Conclusión: La detección temprana del cáncer es una estrategia clave para aumentar las probabilidades de tratamiento exitoso.
No dejes que el miedo o la falta de síntomas te impidan realizar las pruebas necesarias. Consulta con tu médico sobre las opciones de detección adecuadas para ti y toma el control de tu salud hoy mismo.